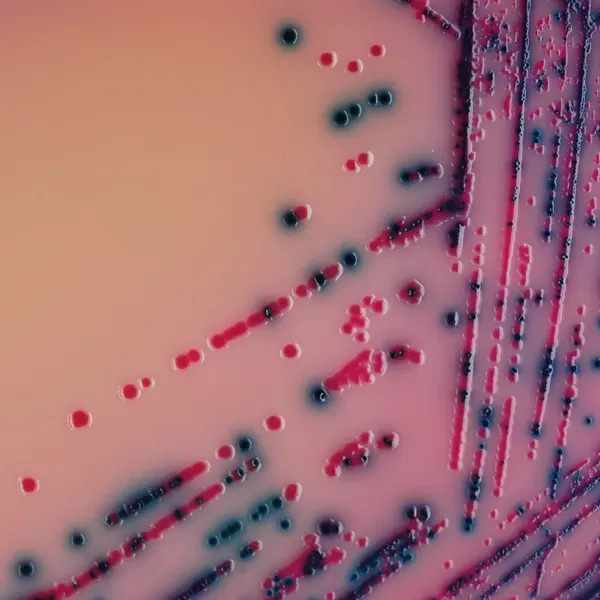
Rambach™ Agar

Hình thái khuẩn lạc
Hiệu năng
Hiệu năng
Bacillus cereus là một vi khuẩn tạo bào tử thường được phân lập từ đất và một số thực phẩm, tạo ra độc tố. Các độc tố này có thể gây ra hai loại bệnh: một loại với đặc trưng tiêu chảy (ủ dài, 8-16 giờ) và một loại khác với buồn nôn và nôn mửa (ủ ngắn, 1-6 giờ).
Dạng ủ ngắn thường liên quan đến các món ăn từ gạo đã được nấu và giữ ấm trong vài giờ.
Ngộ độc thực phẩm B. cereus ủ dài thường liên quan đến thực phẩm có chứa thịt hoặc rau sau khi nấu. Vi khuẩn này đã được phân lập từ đậu và ngũ cốc khô, và từ thực phẩm khô như gia vị, hỗn hợp gia vị và khoai tây.
Dạng bệnh ủ ngắn hoặc nôn mửa được chẩn đoán bằng việc phân lập B. cereus từ thực phẩm nghi ngờ. Dạng bệnh ủ dài hoặc tiêu chảy được chẩn đoán bằng cách phân lập vi khuẩn từ mẫu phân và thực phẩm.
1. Dễ dàng đọc kết quả sau chỉ 24 giờ: ủ 24 giờ ở 30 °C. Khuẩn lạc màu xanh đậm trên môi trường thạch trong suốt giúp dễ dàng đọc kết quả so với thạch dựa trên Mannitol hiện màu đỏ trên thạch hồng.
4. Độ nhạy và độ đặc hiệu cao đối với nhóm cereus so với thạch MYP hoặc Mossel.
Thạch MYP hoặc Mossel cổ điển phụ thuộc vào khả năng không sử dụng mannitol của B. cereus, điều này làm khó khăn cho việc đọc đĩa khi có sự xuất hiện phong phú của vi hệ. CHROMagar™ B.cereus, nhờ công nghệ chromogen, khắc phục khó khăn này.
2. Đơn giản hóa: Khác với thạch MYP hoặc Mossel, không cần thêm nhũ tương lòng đỏ trứng.
5. Thời gian bảo quản đĩa đã chuẩn bị lâu hơn so với thạch MYP và Mossel chỉ có 5 ngày bảo quản.
3. Độ chọn lọc và khôi phục tốt hơn so với môi trường truyền thống so với thạch môi trường truyền thống.
* Độ đặc hiệu và độ nhạy từ Nghiên cứu Khoa học: Nghiên cứu Adria Normandie, 2012.
Thành phần

Tài liệu kỹ thuật
Công bố khoa học
2022
Performance Testing of Bacillus cereus Chromogenic Agar Media for Improved Detection in Milk and Other Food Samples
📄 Publication2012
The evaluation of chromogenic medium for quantitative analysis of B.cereus in Korean traditional sauce
📄 Publication

Xem thêm